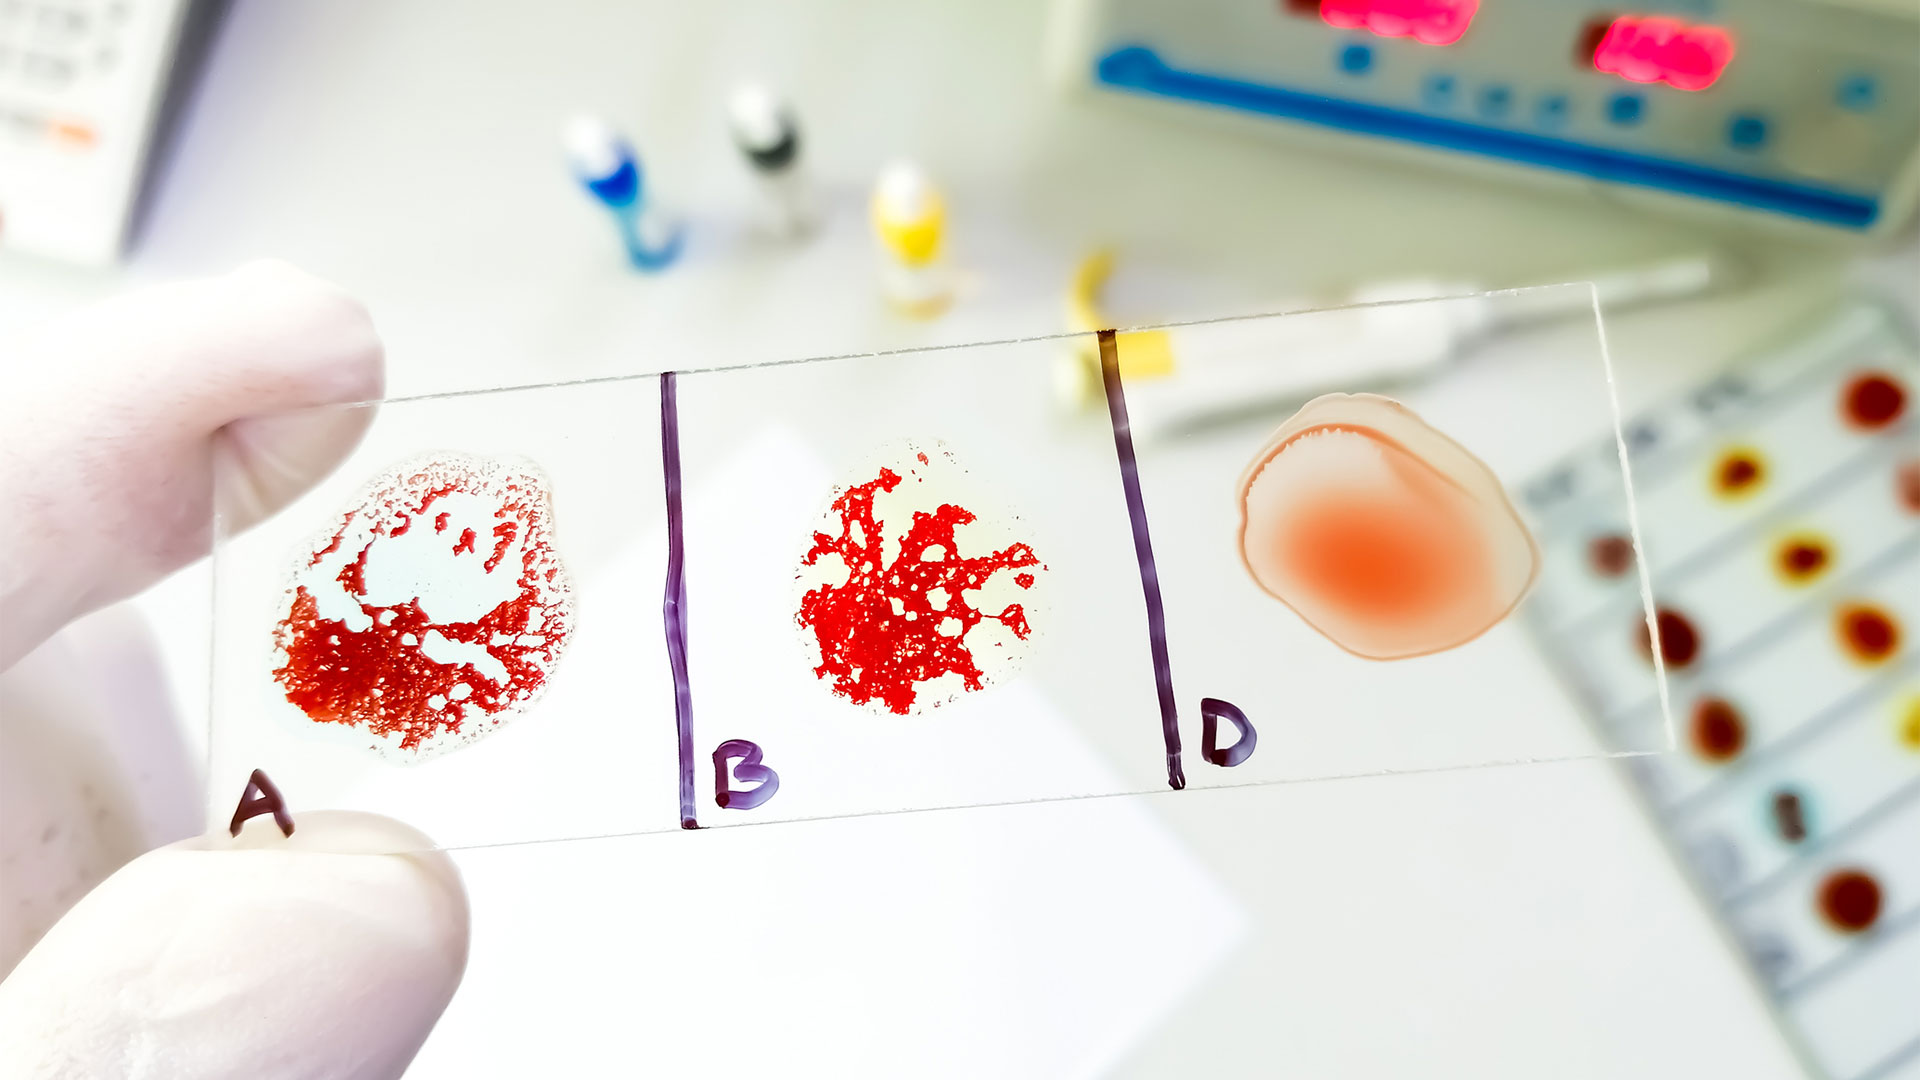
Выявлена ​​группа крови, которая приносит наибольшую пользу для здоровья

Выявлена группа крови, которая приносит наибольшую пользу для здоровья
33 просмотров
Новая работа обнаруживает связь между составом крови, восприимчивостью к инфекциям и старением мозга. Мы разобрались, на что влияет группа крови и можно ли это превратить в преимущество.
I (O): антигенов нет.
II (А): антиген А присутствует.
III (B): Присутствует антиген B.
IV (AB): присутствуют оба антигена.
Современная наука смотрит на проблему гораздо шире. Международное общество переливания крови (ISBT) идентифицирует48 систем групп крови, включающих 398 антигенов. Правда, в клинической практике в основном используют систему АВО и резус-фактор, поскольку они учитывают все критические антигены.
Группа крови и риск тромбоза
Исследования показывают, что группы крови II (A), III (B) и IV (AB) содержат больше белка, называемого фактором фон Виллебранда, циркулирующего в крови. Это увеличивает риск сердечно-сосудистых заболеваний. Согласно исследованиям, в которых использовался фенотип АВО, генетически определенные группы крови, отличные от О, также были связаны с повышенным риском ишемического инсульта и венознойтромбоэмболии, включая сердечные приступы и инсульты.
Группа крови оказывает наибольшее влияние навероятность образования тромбов. По данным Американской кардиологической ассоциации, риск тромбоза глубоких вен и легочной эмболии у людей с I группой крови на 47-51% ниже, чем у людей с другими группами крови.
Ссылка на деменцию
Группа крови, вероятно, может влиять на мозг. Исследование, опубликованное в журнале Neurology, показало, что люди с группой крови IV (AB) имеют больший риск возникновения проблем с памятью и обучением во взрослом возрасте. Возможные механизмы этой связи до конца не изучены.
Что показывает общий анализ крови: инфекции, недостаточность, тромбы
Группа крови и гастрит
Крупное генетическое исследование и систематический обзор, опубликованные в журнале BMC Cancer, разрушают связь между группой крови и заболеваемостью раком желудка и гастритом.Авторы обнаружили, что люди с группами крови II (A) и IV (AB) с большей вероятностью заражаются бактерией Helicobacter pylori, которая вызывает гастрит иповышает риск развивается рак желудка. Эти данные соответствуют более высокой заболеваемости раком желудка среди представителей этой группы крови.
Тяжелая форма COVID-19
Генетический анализ показал, что группа крови может быть связана с тяжестью коронавирусной инфекции. Например, люди с типом I (О) реже попадали в реанимацию с дыхательной недостаточностью, а у пациентов сII (А) группой крови чаще развивались осложнения.
Важно понимать, что группа крови является лишь одним из факторов риска и далеко не ключевым. Здоровье гораздо сильнее влияет на образ жизни и, в отличие от антигенов в крови, его можно изменить. Воспользуйтесь умными решениями, которые помогут вам позаботиться о своем здоровье и финансах.
Подписывайтесь на в Максе! Мы останемся на связи, несмотря на блокировки и сбои.

